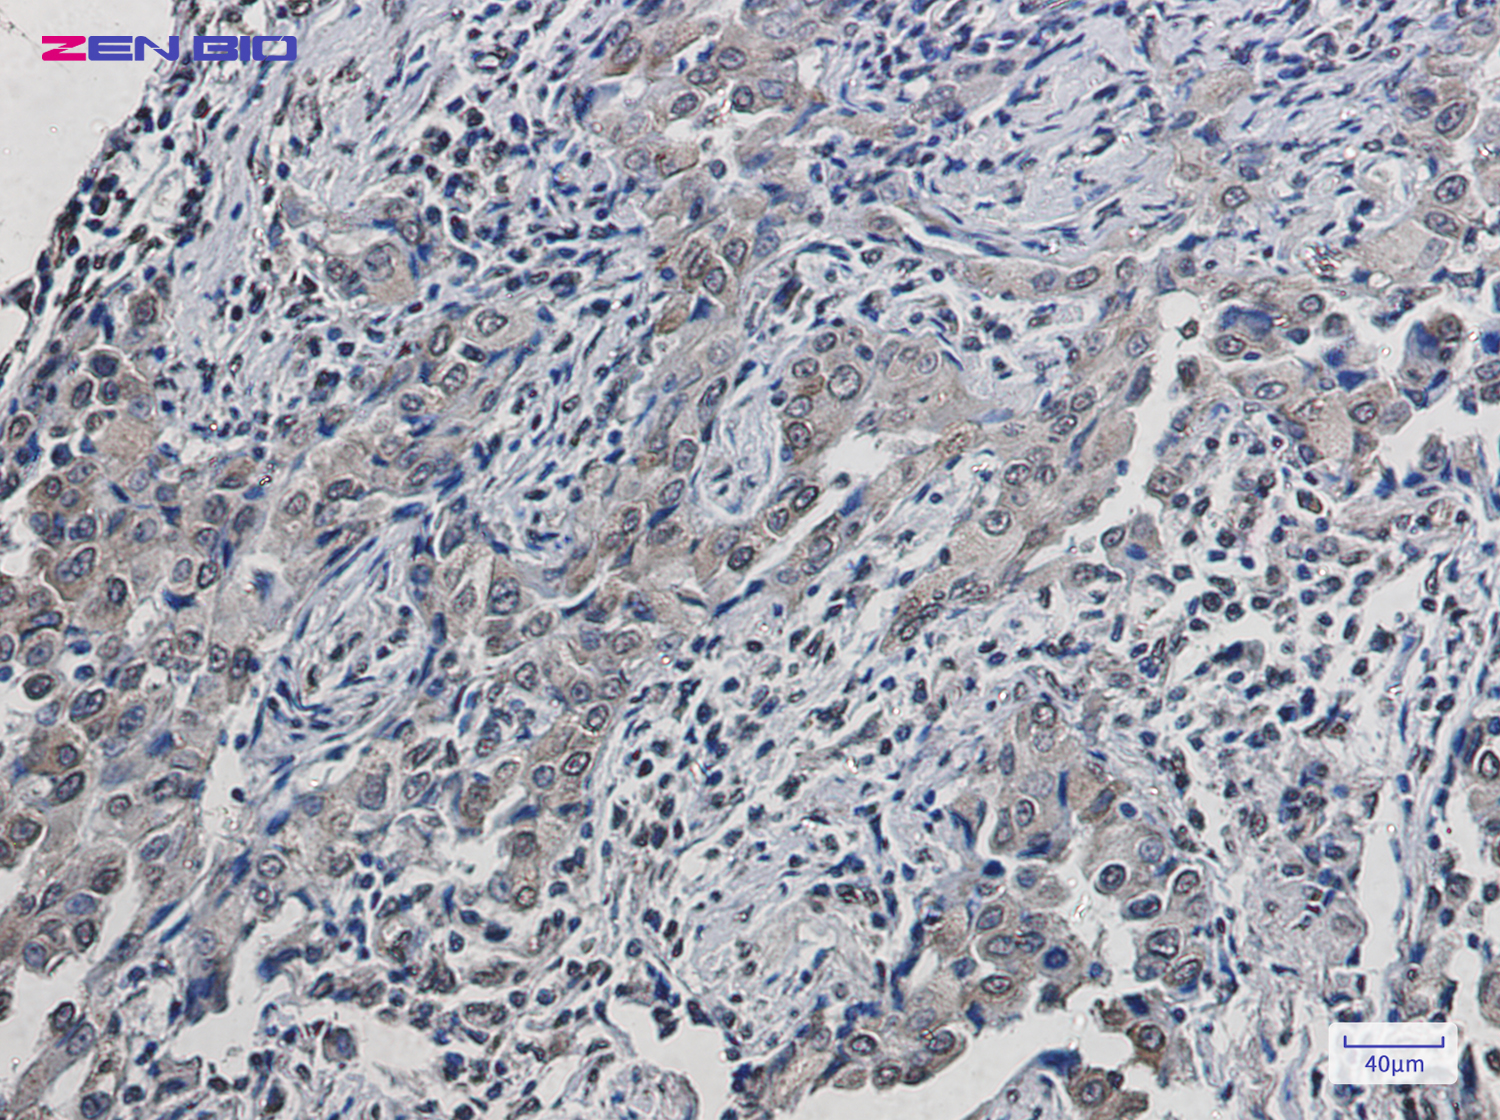
Immunohistochemistry of SCD1 in paraffin-embedded Human lung cancer tissue using SCD1 Rabbit pAb at dilution 1/50

-
Product Name
Anti-SCD1 Rabbit antibody
- Documents
-
Description
SCD1 Rabbit polyclonal antibody
-
Tested applications
WB, IHC-P, ICC/IF, FC, IP
-
Species reactivity
Human, Mouse, Rat
-
Alternative names
SCD1; FADS5; SCDOS; hSCD1; MSTP008 antibody
-
Isotype
Rabbit IgG
-
Preparation
Antigen: Recombinant protein of human SCD1
-
Clonality
Polyclonal
-
Formulation
Supplied in 50nM Tris-Glycine(pH 7.4), 0.15M Nacl, 40%Glycerol, 0.01% sodium azide and 0.05% BSA.
-
Storage instructions
Store at -20°C. Stable for 12 months from date of receipt.
-
Applications
WB: 1/1000
IHC: 1/200
ICC/IF: 1/20
FC: 1/20-1/100
IP: 1/20
-
Validations
Immunohistochemistry of SCD1 in paraffin-embedded Human lung cancer tissue using SCD1 Rabbit pAb at dilution 1/50

Western blot detection of SCD1 in Hela cell lysates using SCD1 Rabbit pAb(1:1000 diluted).Predicted band size:42kDa.Observed band size:37kDa.

Immunocytochemistry of SCD1(green) in Hela cells using SCD1 Rabbit pAb at dilution 1/50, and DAPI(blue)
-
Background
Swiss-Prot Acc.O00767.Stearyl-CoA desaturase that utilizes O2 and electrons from reduced cytochrome b5 to introduce the first double bond into saturated fatty acyl-CoA substrates (PubMed:15907797, PubMed:18765284). Catalyzes the insertion of a cis double bond at the delta-9 position into fatty acyl-CoA substrates including palmitoyl-CoA and stearoyl-CoA (PubMed:15907797, PubMed:18765284). Gives rise to a mixture of 16:1 and 18:1 unsaturated fatty acids (PubMed:15610069). Plays an important role in lipid biosynthesis. Plays an important role in regulating the expression of genes that are involved in lipogenesis and in regulating mitochondrial fatty acid oxidation . Plays an important role in body energy homeostasis . Contributes to the biosynthesis of membrane phospholipids, cholesterol esters and triglycerides .
Related Products / Services
Please note: All products are "FOR RESEARCH USE ONLY AND ARE NOT INTENDED FOR DIAGNOSTIC OR THERAPEUTIC USE"
